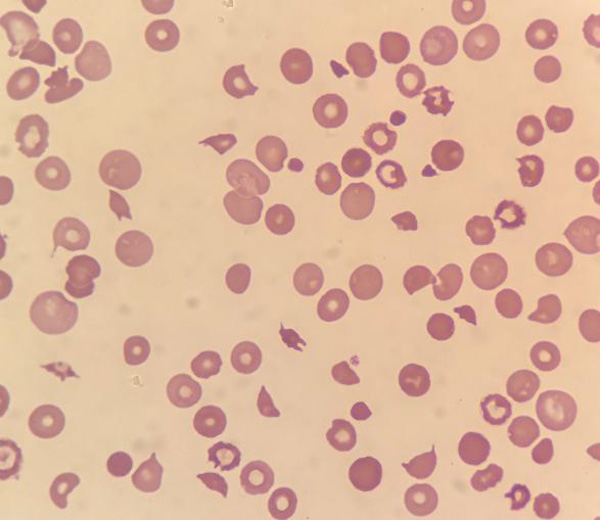

提起医学检验科,可能很多人都会说,不就是化验室吗?其实远远没有那么简单,现代医学检验中的“检”是检测、检查,重点在分析中的质量控制,“验”则是指校验、验证,重点在分析后的质量控制,发现分析前产生的问题,检验结果的解释、进一步检查的建议都是其业务范围。
近年来血液系统疾病发病率逐年增高,其诊断随着免疫学、细胞遗传学、分子生物学的发展而快速发展。目前以WHO(世界卫生组织)提倡的MICM(细胞形态学、免疫学、细胞遗传学、分子生物学)综合诊断为主,而血细胞形态学仍是最基础的手段,也是柳州市人民医院医学检验科骨髓细胞室的主要检验项目,力求精准诊断,及早提供血液系统疾病方面的信息,为临床诊治提供直接而充足的依据。
近日蓝先生在外院检查考虑为多发性骨髓瘤,抱着对柳州市人民医院的信任,转至我院血液内科。入院后,医生非常重视蓝先生的病情,特地联系检验科骨髓细胞室关注蓝先生的骨髓涂片及血涂片。

检验科骨髓细胞室检验人员在血涂片镜下发现一类胞体小、呈圆形、胞核居中、胞浆量少且偏蓝色的细胞。此类细胞既不像典型淋巴细胞,也不像典型浆细胞。结合骨髓涂片细胞形态,考虑该类细胞为肿瘤性浆细胞,其比例已达到浆细胞白血病的诊断标准。此时骨髓细胞室考虑浆细胞白血病的结论与外院诊断多发性骨髓瘤结果存在出入。为进一步明确蓝先生的病因,骨髓细胞室建议临床做针对浆细胞白血病做进一步检验。不出所料,免疫学、细胞遗传学及分子生物学检查结果与骨髓细胞室形态学报告相符。

浆细胞白血病(plasma cell leukemia,PCL)是一种罕见的侵袭性浆细胞恶性肿瘤,恶性程度高,预后差,早发现早治疗方能提高患者生存率。该病诊断的关键点及难点在于外周血细胞及时准确发现浆细胞及其比例,稍有偏差就容易误判。骨髓细胞室医务人员凭借专业技术水平和严谨的阅片态度,及时提供准确的诊断,对临床及时明确疾病病因和患者的诊治中起到了关键作用。
江女士因淋巴结肿大来到柳州市人民医院就诊,经淋巴结活检确诊为淋巴瘤,在治疗之前需通过骨髓涂片及骨髓活检来确定是否存在骨髓侵犯。骨髓活检结果未发现淋巴瘤细胞,但在骨髓涂片见有个别细胞形态异常且多样,经多人阅片校对,最终诊断该类细胞为淋巴瘤细胞,给予临床意见为考虑淋巴瘤骨髓侵犯。对极少量淋巴瘤细胞侵犯骨髓时,骨髓活检组织常难鉴别其形态特点,检出率低,针对这一难点,骨髓涂片却可以解决。

涂片可清晰分辨细胞的形态,却非常考验阅片人对淋巴瘤细胞形态的掌握,骨髓细胞室检验人员克服了技术困难,揪出真相。后续患者骨髓免疫分型结果与骨髓细胞形态学一致,明确为淋巴瘤骨髓侵犯。这例骨髓细胞形态学报告及时向临床提供患者骨髓真实信息,保障患者得到及时准确诊治,提高了治疗效果。
张女士6天前于外院分娩,分娩前血常规检查各项指标正常。产后出现流血,血常规检查提示贫血及血小板进行性减少,尿色浓茶样改变,为进一步诊治转入我院。入院后出现头晕、少语等意识障碍。

骨髓细胞室阅血涂片见较多破碎红细胞,考虑为血栓性血小板减少性紫癜(TTP),立即以危急值形式报告临床,并建议做针对性检查。
经检查结果确定了TTP的诊断,通过血浆置换治疗后,张女士病情好转出院。TTP是一种临床少见的、致命的血栓性微血管病,涉及多个系统,病情复杂且进展迅速,死亡率高,但如能及早诊断及治疗,能大大提高生存率。血涂片细胞形态对及早诊断TTP作用大,能一眼定乾坤。
“随着医学的快速发展,检验科与临床联系更加紧密。加强检验科与临床之间的交流,强化有效沟通,才能为临床治疗提供科学、准确的诊疗依据。”医学检验科主任唐石伏介绍,在保证检验结果准确的基础上,为临床提供合理的结果解释,根据异常检验线索提出需要增加的检验需求,为临床诊治提供有力支持,才能实现检验工作更好地服务于临床,服务于患者。

每当诊断罕见或疑难病例后,医学检验科骨髓细胞室均及时整理病例资料,在国内血液病整合诊断讨论群进行分享讨论,通过与专家交流沟通,提高专科技术水平和积累疑难病例的经验,同时,骨髓细胞室人员还将专家讨论的意见与我院血液科医生进行分享学习,通过一个病例的诊断讨论、分享讨论再到总结学习,助力临床的同时,时刻提高自身能力,为广大患者提供更优质准确的医学检验服务。
柳州市人民医院医学检验科骨髓细胞室是从事血细胞形态学的医学检验实验室,现有4名检验人员,其中副主任技师1人、主治医师1人,主管技师2人,3人具有检验医师资格,在读研究生3人。

配备多台高级生物显微镜,开展骨髓细胞形态学、外周血细胞形态学及肺泡灌洗液形态学等项目检查。有全套细胞形态学染色项目,可进行各类常见血液疾病诊断,并辅助诊断一些少见病例,诊断结果与临床符合率高。注重报告质量,采取双人阅片、分级阅片、疑难病例讨论及病例追踪等工作模式,注重MICM诊断。2021年参与临床疑难病例会诊13次,2021年完成造血干细胞移植项目形态学标本95份。具备规培生、实习生带教实力,全程实施一对一教学模式,教学质量佳,为全区各级医疗机构培养了大批血液学检验专业人才。团队人员技术水平高,年轻成员有担任白求恩精神研究会检验医学分会理事和细胞形态学检验诊断专业委员会委员。

近年来陆续在广西寄生虫防治技术竞赛获得团体二等奖、血液病诊断论坛形态学大赛中获二等奖、白求恩精神研究会广西检验医学专业委员会第一届细胞形态学大赛团体一等奖。